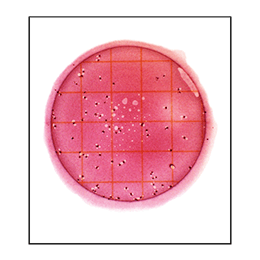
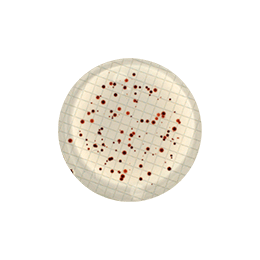

- Todos los productos
- Todos los productos
- Scan 4000 es un contador de colonias automático y AD. Su sistema de iluminación provee comodidad, precisión y alta reproducibilidad. Variantes: [438000Scan4000Contadorautom] Scan 4000 - Descárguela y compruebe su eficacia con sus muestras.
Scan 4000 es un contador de colonias automático y AD. Su sistema de iluminación provee comodidad, precisión y alta reproducibilidad. Variantes: [438000Scan4000Contadorautom] Scan 4000 - Descárguela y compruebe su eficacia con sus muestras.
https://cotecno.opendrive.cl/shop/n4000-scan-4000-es-un-contador-de-colonias-automatico-y-ad-su-sistema-de-iluminacion-provee-comodidad-precision-y-alta-reproducibilidad-variantes-438000scan4000contadorautom-scan-4000-descarguela-y-compruebe-su-eficacia-con-sus-muestras-451187 https://cotecno.opendrive.cl/web/image/product.template/451187/image_1920?unique=4aeb949
Términos y condiciones
Garantía de devolución de 30 días
Envío: 2-3 días laborales
Ref. 438 000
Presentación
Versión demo gratuita del software Scan
Descárguela y compruebe su eficacia con sus muestras.

La gama más amplia del mercado
El Scan 4000 permite lecturas en placas de Petri de hasta 150 mm de diámetro, y en Petri cuadradas de 120 mm. Esto hace del Scan 4000 el contador de colonias con más posibilidades del mercado, para máxima flexibilidad en el uso. El Scan 4000 es también un lector de zonas de inhibición en placas de Petri redondas o cuadradas.
- Recuento de colonias
- Lectura de zonas de inhibición
En masa y superficie

Spiral

Círculo

Cromogénico

PetriFilm TM Compact Dry TM MC-Media Pads TM Easy Plate TM

Membranas de filtración

Ø 150 mm

Ø 90 mm

120 mm cuadrada

Precisión y repetibilidad
El recuento en una placa de Petri es largo, tedioso y puede variar de una persona a otra. El Scan 4000 puede contar hasta 1000 colonias en 1 segundo de manera constante y repetible. La precisión del recuento alcanza el 98%. El tamaño minímo de colonia detectada es 0.05 mm.
Flora total antes/después del recuento

Precisión y repetibilidad
El recuento en una placa de Petri es largo, tedioso y puede variar de una persona a otra. El Scan 4000 puede contar hasta 1000 colonias en 1 segundo de manera constante y repetible. La precisión del recuento alcanza el 98%. El tamaño minímo de colonia detectada es 0.05 mm.
Recuento manual

Recuento automático

21 CFR Part 11 incluido
El software Scan cumple con las recomendaciones de la FDA, incluyendo el audit trail y la seguridad de los resultados.
La gestión de las cuentas de usuario, integrada en el software, permite la creación de 5 niveles de derechos. El supervisor-administrador tiene todas las funciones, mientras que las demás funciones están sujetas a ciertos derechos. La administración de contraseñas asegura las cuentas de los usuarios.

Trazabilidad
- Importación de datos
- Grabación de datos
- Exportación de datos
Conexión SIL/LIMS
Código de barras
data Link
Scan 4000 se conecta al LIMS bidireccionalmente y puede ser conectado al diluidor y al sembrador via el sistema de trazabilidad data Link .
CSV
Después de cada recuento validado, el Scan 4000 guarda y exporta automáticamente los parámetros de recuento y los resultados a un archivo CSV .
Conexión SIL/LIMS
Pista de auditoría
Respaldo y archivo de sesiones
JPG, PNG, BMP
Excel TM OpenOffice TM
CSV
Scan 4000 ofrece múltiples posibilidades de exportar datos y ahorrar tiempo de transcripción. También aumenta la seguridad y la calidad de sus análisis . Usualmente, las placas de Petri son desechadas después del recuento, y la verificación posterior de datos no es posible en el caso de que haya un problema. Con Scan 4000, todos los informes son registrados.
Exporte sus resultados a su ordenador o regístrelos en CSV , Excel TM , OpenOffice TM , PDF , SCA , BIO . También podrá exportar imágenes de la cámara en JPEG , PNG y formato BMP .
Impresión de resultados
Todos los datos, imágenes, fotos y resultados son exportables en informes impresos, sca, pdf, jpg, xls, csv.
Ejemplo de informe impreso

Iluminación en domo con LED blancas: sin reflejos ni sombras
Las placas de Petri son difíciles de iluminar porque son transparentes y reflectantes. La iluminación heterogénea crea artefactos en los bordes del agar y en los costados de la placa. Estos artefactos pueden ser falsamente contados como colonias y alterar el resultado final del recuento.
Hemos diseñado un domo de luces LED blancas que difunden 360° de iluminación, sin reflejos ni sombras. La luz se dispersa uniformemente en todos los puntos, y permite una iluminación sin artefactos. El recuento puede hacerse incluso en los bordes de la placa.



Cámara de ultra alta resolución
Equipado con una cámara alemana de 5 megapíxeles y una lente japonesa, el Scan 4000 ofrece la mejor calidad de imágen de la gama Interscience, para ver hasta los detalles más ínfimos que no vería con sus propios ojos.
Lectura en 100% de la superficie de la placa de Petri

Coloque la placa de Petri donde quiera, el Scan 4000 la detecta y la amplifica automáticamente. Puede contar las colonias en el 100% de la superficie de la placa, sin omitir las colonias ubicadas en los meniscos del agar.
Lectura en 100% de la superficie de la placa de Petri
Coloque la placa de Petri donde quiera, el Scan 4000 la detecta y la amplifica automáticamente. Puede contar las colonias en el 100% de la superficie de la placa, sin omitir las colonias ubicadas en los meniscos del agar.

Garantice la trazabilidad con data Link
Con data Link , puede realizar un seguimiento de la muestra desde la siembra hasta el conteo automático de colonias.
Personalice la etiqueta que se pegará en el borde de la placa de Petri. A continuación, se optimiza el recuento de colonias.
Garantía
Los contadores automáticos de colonias Scan tienen 3 AÑOS de garantía (repuestos y mano de obra) bajo envío de la tarjeta de garantía.
Aplicaciones
Se usa el contador de colonias Scan en las industrias alimentaria, ambiental, farmacéutica, cosmética, veterinaria y en institutos de investigación públicos.
Videos
Desde preparación de la muestra hasta análisis bacteriano - Presentación
Scan 4000 - Contador de colonias automático: Presentación (inglés)
Unboxing - Contadores de colonias automáticos: modelo Scan 4000 (inglés)
data Link pro - Etiquete en el borde de la placa de Petri
Recursos
- Productos
- Notas de aplicación
- Artículos científicos
- Accesorios
Publicación: 2023
Publicación: 2021
Especificaciones
Conforme a una utilización siguiendo las Buenas Prácticas de Laboratorio (BPL)
Producto fabricado para Interscience por Interlab, empresa certificada ISO 9001.
- Referencia: Scan 4000: 438 000
VISIÓN GENERAL
- Carcasa de acero inoxidable pintada: Scan 4000: N
- Conexión LIMS/SIL: Scan 4000: N
- Conexión USB: Scan 4000: N
- Disponible con sistema de trazabilidad dataLink / dataLink pro: Scan 4000: N
- Recuento en placa de Petri en modo masa, superficie, espiral y círculo: Scan 4000: N
- Recuento en placas cromogénicas: Scan 4000: N
- Recuento en PetrifilmTM, Compact DryTM, MC-Media PadTM, Easy PlateTM, membranas de filtración: Scan 4000: N
- Recuento automático: Scan 4000: N
- Lector de zonas de inhibición: Scan 4000: N
- Recuento en 100% de las placas de Petri: Scan 4000: N
RECUENTO DE COLONIAS
- Recuento: Scan 4000: Automático con control manual
- Separación automática de colonias confluentes: Scan 4000: N
- Creación de zonas de exclusión poligonales: Scan 4000: N
- Tiempo de recuento: Scan 4000: Hasta 1000 colonias por segundo
- Tamaño mínimo de la colonia: Scan 4000: 0.05 mm
LECTURA DE LAS ZONAS DE INHIBICIÓN
- Detección de los discos de antibióticos: Scan 4000: Automático con la posibilidad de añadir o quitar los antibióticos manualmente
- Detección automática de los diferentes medios y soportes de antibiogramas: Scan 4000: Discos (varias marcas), pozos, penicilindros (acero, plástico)
- Resolución de pantalla: Scan 4000: ± 0.1 mm
- Precisión de la medida de zona de inhibición: Scan 4000: ± 0.2 mm
- Número de antibióticos por disco de papel: Scan 4000: Hasta 16 antibióticos en placa cuadradas de 120 mm
- Tiempo de lectura: Scan 4000: 16 lecturas de zonas de inhibición entre 2 y 4 segundos máx
- Sistema de interpretación: Scan 4000: CA-SFM Human health / EUCAST / CA-SFM Veterinary / CLSI (Clinical, Laboratory Standards Institute) / lista ajustable
ESPECIFICATIONES
- Cámara de color: Scan 4000: Ultra HD CMOS
- Lente: Scan 4000: Lente japonés HD
- Zoom: Scan 4000: x 69
- Resolución (megapixeles): Scan 4000: 5
- Tecnología de iluminación indirecta por LED blanco: Scan 4000: White LED Dome
- Sistema de iluminación LED: Scan 4000: Automático con 7 combinaciones, luz arriba y abajo, fondo blanco o negro
- Tamaño de la placa de Petri: Scan 4000: De Ø 55 a Ø 150 mm y placas de Petri cuadradas de 120 mm
- Detección de colores: Scan 4000: 7 colores en la misma placa + 1 color de exclusión
- Voltaje - Frecuencia: Scan 4000: 100-240 V~ 50-60 Hz
- Fusibles: Scan 4000: T3.15A L 250V 5x20 mm
- Max. potencia: Scan 4000: 140 W
- Indice de protección: Scan 4000: IP00
- Garantía: Scan 4000: 3 años (empieza después del registro de la tarjeta de garantía)
- Disponibilidad de piezas de recambio: Scan 4000: 10 años
- Cumple con:: Scan 4000: 21 CFR Part 11, ISO 7218 & AOAC 977.27
- Idiomas: Scan 4000: inglés, francés, japonés, chino, ruso, español, alemán
- Actualización del software: Scan 4000: 3 años tras el registro de la carta de garantía (cualificación no incluida)
TRAZABILIDAD
- Actualización del software: Scan 4000: Sesión de recuento, PDF, jpg, png, bmp, Excel TM
- Seguridad de datos: Scan 4000: Trazabilidad de datos modificados en conformidad con 21 CFR part 11
- Resultados / Trazabilidad: Scan 4000: Imagen / número de muestra / comentarios / fecha / hora / nombre del antibiótico / nombre de la bacteria / diámetro medido / resultado categorizado según normas / diámetro crítico mínimo y máximo
REQUISITOS MÍNIMOS
- Sistema operativo: Scan 4000: Windows TM : 10 o 11 o superior
- Procesador: Scan 4000: Intel i5 2.8 GHz, quad core o mejor
- RAM: Scan 4000: 4 GB de RAM deben reservarse para el uso del Scan
- Equipos: Scan 4000: Puerto USB libre
- Pantalla: Scan 4000: 1280 X 1024 píxeles o superior
PESO Y DIMENSIONES
- Dimensiones (a x p x a): Scan: Scan 4000: 47 x 47 x 64 cm
- Peso neto: Scan: Scan 4000: 25.15 kg
- Dimensiones de la caja (a x p x a): Scan 4000: 80 x 60 x 63 cm
- Peso bruto: Scan: Scan 4000: 32.5 kg
INCLUYE
Accesorios

Limpiador óptico y toallitas

Lector de código de barras
Productos complementarios
PetriPile
Soporte para placas de Petri
Soporte para placas de Petri
Sembradores automáticos
Solución de etiquetado de placas de Petri
Recursos descargables
- - Folleto Scan 4000 (PDF, 5.4 MB, idioma: Inglés) → https://www.interscience.com/IMG/pdf/interscience_scan4000_b_en_web.pdf
- - Folleto sistema Plate & Count (PDF, 10.8 MB, idioma: Inglés) → https://www.interscience.com/IMG/pdf/interscience_plate_count_brochure_en_web.pdf
- - Ficha técnica Scan 4000 (PDF, 306.4 KB, idioma: Inglés) → https://www.interscience.com/IMG/pdf/interscience_scan4000_ft_en.pdf
- - Ficha técnica Lector de códigos de barras (PDF, 235.3 KB, idioma: Inglés) → https://www.interscience.com/IMG/pdf/interscience_barcodereader_ft_en.pdf
- - Certificado EC (PDF, 107.5 KB, idioma: Inglés) → https://www.interscience.com/IMG/pdf/interscience_ec_certificate_colony_counters_and_lab_accessories_en.pdf
- - Certificado ISO 9001 (PDF, 557.3 KB, idioma: francés, Inglés) → https://www.interscience.com/IMG/pdf/interscience_certificat_iso_9001-2015_fr-en_-_2024-2027.pdf
- - Certificado 21 CFR (PDF, 198.4 KB, idioma: Inglés) → https://www.interscience.com/IMG/pdf/interscience_certificat_cfr21part11-en.pdf
- - Ficha de datos de seguridad Purosol (PDF, 113.9 KB, idioma: Inglés) → https://www.interscience.com/IMG/pdf/interscience_purosol_fds_en.pdf
- - Catálogo en Español (PDF, 4.5 MB, idioma: Español) → https://www.interscience.com/IMG/pdf/interscience_catalogue_es_web.pdf
- - Nota de aplicación: Evaluación de rendimiento Scan 1200 (PDF, 3.2 MB, idioma: Inglés) → https://www.interscience.com/IMG/pdf/scan_1200_applicationnote_en.pdf
- - Publicación: 2023 La química de superficie determina las propiedades osteogénicas y antimicrobianas de los vidrios metálicos a granel basados en paladio, platino y titanio (PDF, 5.1 MB, idioma: Inglés) → https://www.interscience.com/IMG/pdf/advanced-functional-materials-2023-en.pdf
- - Publicación: 2021 Asociación de la fuerza de prensión de la mano y la resistencia con la composición corporal en pacientes con cáncer de cabeza y cuello (PDF, 584.3 KB, idioma: Inglés) → https://www.interscience.com/IMG/pdf/journal-family-medicine-primary-care-2021-en.pdf
![Scan 4000 es un contador de colonias automático y AD. Su sistema de iluminación provee comodidad, precisión y alta reproducibilidad. Variantes: [438000Scan4000Contadorautom] Scan 4000 - Descárguela y compruebe su eficacia con sus muestras.](/web/image/product.product/2001389/image_128/%5BN4000%5D%20Scan%204000%20es%20un%20contador%20de%20colonias%20autom%C3%A1tico%20y%20AD.%20Su%20sistema%20de%20iluminaci%C3%B3n%20provee%20comodidad%2C%20precisi%C3%B3n%20y%20alta%20reproducibilidad.%20Variantes:%20%5B438000Scan4000Contadorautom%5D%20Scan%204000%20-%20Desc%C3%A1rguela%20y%20compruebe%20su%20eficacia%20con%20sus%20muestras.?unique=4aeb949)








![Scan 4000 es un contador de colonias automático y AD. Su sistema de iluminación provee comodidad, precisión y alta reproducibilidad. Variantes: [438000Scan4000Contadorautom] Scan 4000 - Descárguela y compruebe su eficacia con sus muestras.](/web/image/product.product/2001389/image_1024/%5BN4000%5D%20Scan%204000%20es%20un%20contador%20de%20colonias%20autom%C3%A1tico%20y%20AD.%20Su%20sistema%20de%20iluminaci%C3%B3n%20provee%20comodidad%2C%20precisi%C3%B3n%20y%20alta%20reproducibilidad.%20Variantes:%20%5B438000Scan4000Contadorautom%5D%20Scan%204000%20-%20Desc%C3%A1rguela%20y%20compruebe%20su%20eficacia%20con%20sus%20muestras.?unique=4aeb949)